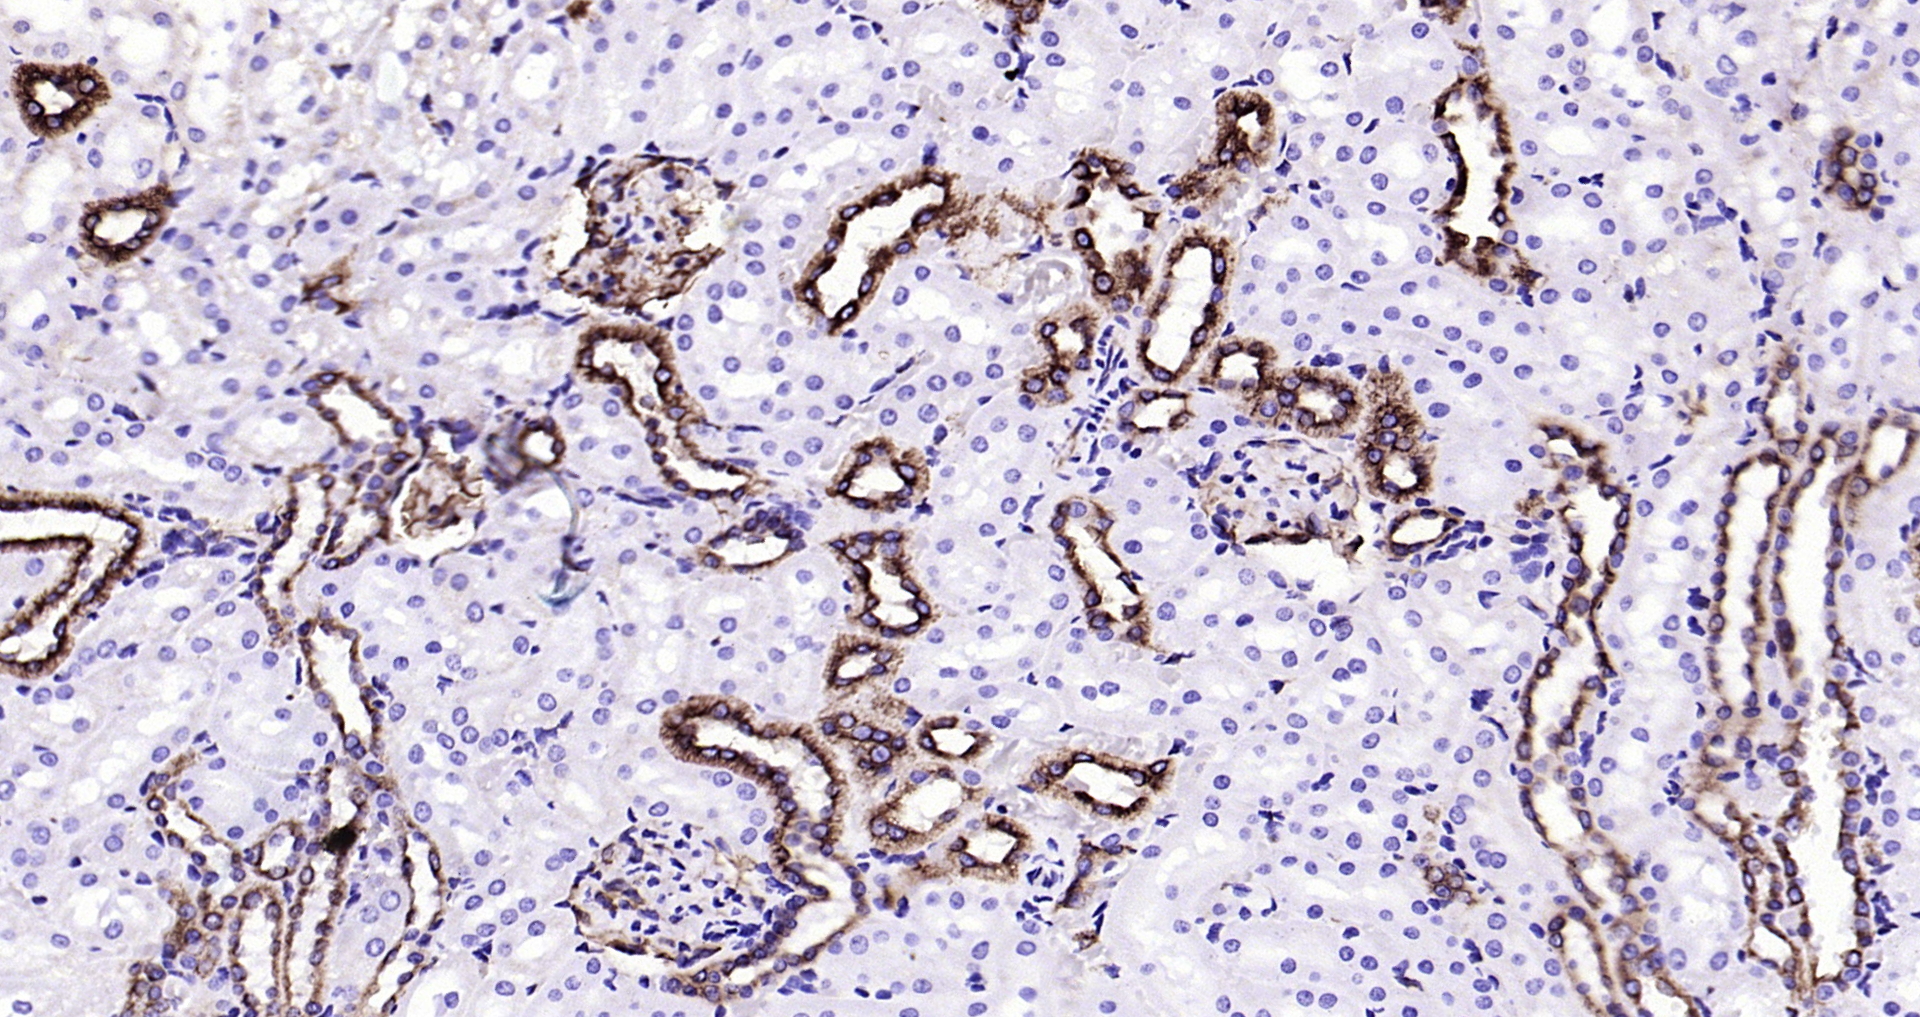
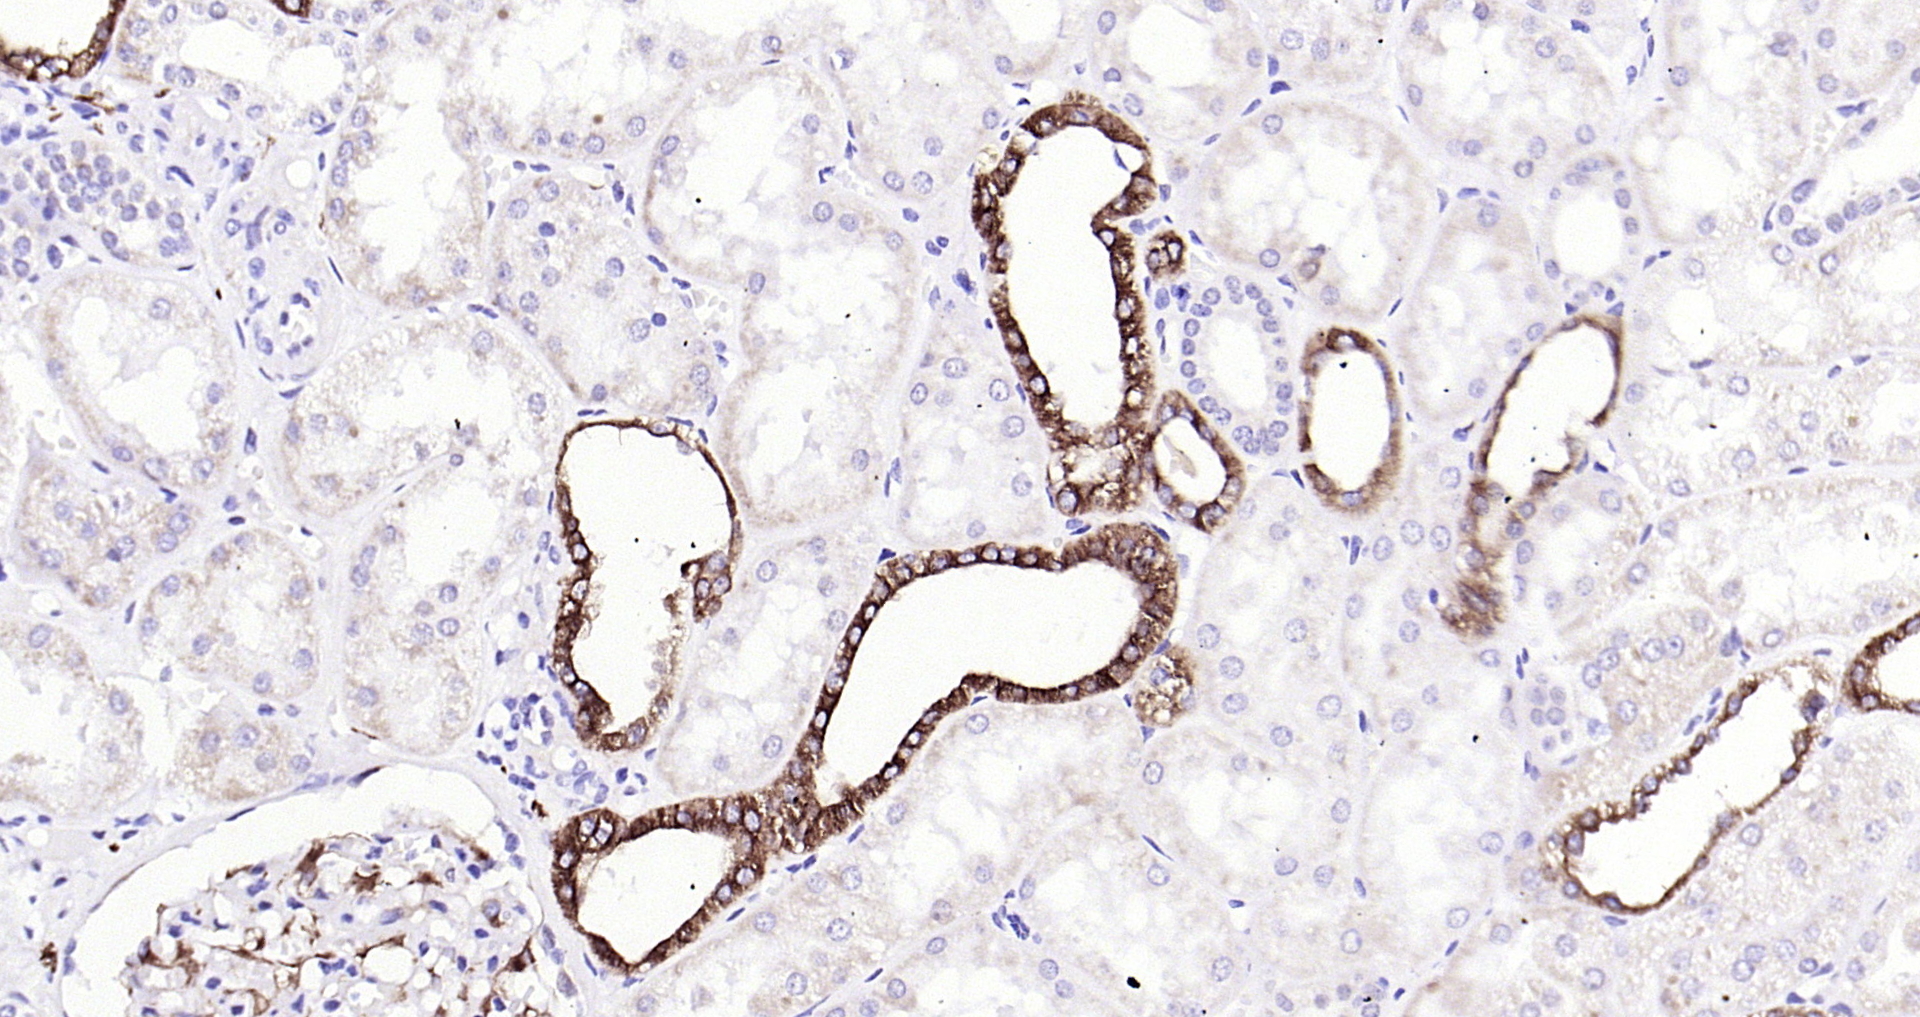

IF(ICC) staining with Ephrin B2 (3A7) Monoclonal Antibody (bsm-54090R) at 1:100 in 293T cells (green). The nuclear counterstain is DAPI (blue). Cells were fixed in paraformaldehyde, permeabilized with 0.25% Triton X100/PBS.
Ephrin B2 Recombinant Antibody
BSM-54090R
ApplicationsImmunoFluorescence, Western Blot, ImmunoHistoChemistry, ImmunoHistoChemistry Frozen, ImmunoHistoChemistry Paraffin
Product group Antibodies
ReactivityHuman, Mouse, Rat
TargetEFNB2
Overview
- SupplierBioss
- Product NameEphrin B2 Recombinant Antibody
- Delivery Days Customer16
- ApplicationsImmunoFluorescence, Western Blot, ImmunoHistoChemistry, ImmunoHistoChemistry Frozen, ImmunoHistoChemistry Paraffin
- Applications SupplierWB(1:300-5000), IHC-P(1:200-400), IHC-F(1:100-500), IF()
- CertificationResearch Use Only
- ClonalityMonoclonal
- Concentration1 ug/ul
- ConjugateUnconjugated
- Gene ID1948
- Target nameEFNB2
- Target descriptionephrin B2
- Target synonymsEPLG5, HTKL, Htk-L, LERK5, ephrin-B2, ephrin-B2, HTK ligand, eph-related receptor tyrosine kinase ligand 5, ligand of eph-related kinase 5
- HostRabbit
- IsotypeIgG
- Protein IDP52799
- Protein NameEphrin-B2
- ReactivityHuman, Mouse, Rat
- Storage Instruction-20°C
- UNSPSC41116161